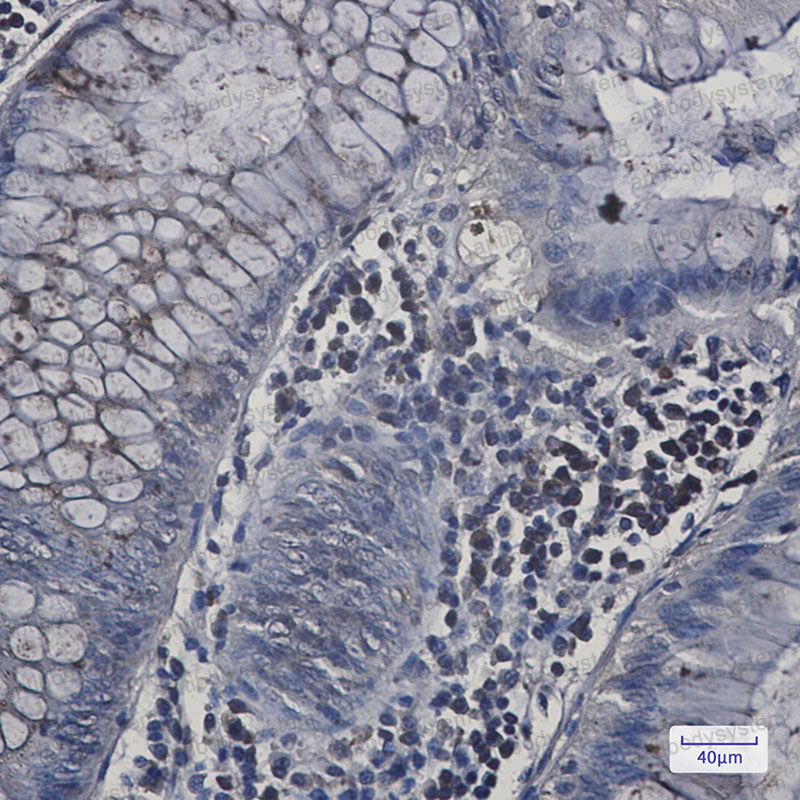
Валидация AntibodySystem RHA10501

| UNIPROT | O00401 |
Anti-WASL Antibody (R1C86) (RHA10501)
Реактивность подтвержденная:
человек, мышь
Источник (хозяин):
кролик
Валидировано для:
IF
IHC
WB
Характеристики
Техническое описание
| Русское название | RHA10501 Моноклональное антитело к WASL (R1C86) <AntibodySystem,Китай> |
| Каталожный номер | RHA10501 |
| Название антигена | Neural Wiskott Aldrich Syndrome Protein (NWASP) |
| UNIPROT | O00401 |
| Английские синонимы | WASL, N-WASP, Wiskott-Aldrich Syndrome-Like |
Реактивность подтвержденная Нужна другая реактивность? |
человек, мышь |
| Источник (хозяин) | кролик |
| Изотип | IgG |
| Клональность | моноклональное |
| Клон | R1C86 |
| Рекомбинантное | да |
| Готовое к использованию | нет |
| Концентрация | 1 мг/мл |
| Конъюгат | нет |
| Валидировано для | IF IHC WB Иммунофлуоресценция; Иммуногистохимия; Вестерн-блоттинг |
| Рекомендуемые разведения | IF: 1:50-1:200, IHC: 1:50-1:100, WB: 1:500-1:1000 |
| Метод очистки | Очистка с белками A/G из супернатанта клеточной культуры |
| Чистота | >95% |
| Состав буфера | 0.01M PBS, pH 7.4, 0.05% БСА, 50% глицерин, 0.05% азид натрия |
| Условия доставки | термобокс с аккумуляторами холода |
| Условия хранения | Хранить при -20 С -12 месяцев |
| Срок хранения | 12 месяцев |
| Производитель | AntibodySystem |
| Ссылка на страницу товара на сайте производителя | https://www.antibodysystem.com/product/29937.html |
|
Артикул
|
Наименование |
Производитель
|
|---|
|
Артикул
|
Наименование |
Производитель
|
|---|
|
Артикул
|
Наименование |
Производитель
|
|---|
Акции и предложения
Популярные продукты:
Sheep Corneodesmosin ELISA kit (E14C0406)
Организм: овца
Mouse Antithrombin III(AT III) ELISA kit (E03A1970)
Организм: мышь
Human Antithrombin III(AT III) ELISA kit (E01A1970)
Организм: человек
Диапазон определения: 50-1000 мкг/мл
Чувствительность: 1 мкг/мл
Диапазон определения: 50-1000 мкг/мл
Чувствительность: 1 мкг/мл
Sheep Vitamin E (VE) Elisa kit (E14V0032)
Организм: овца
Chicken Vitamin E (VE) Elisa kit (E12V0032)
Организм: курица
Диапазон определения: 0.5-10 мкг/мл
Чувствительность: 0.1 мкг/мл
Диапазон определения: 0.5-10 мкг/мл
Чувствительность: 0.1 мкг/мл
Chicken Vitamin C ELISA kit (E12V0022)
Организм: курица